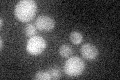
YPL202C
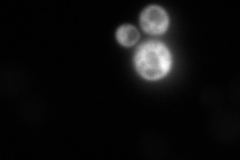
YPL202C
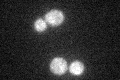
YPL202C

View description
Iron-regulated transcriptional activator; activates genes involved in intracellular iron use and required for iron homeostasis and resistance to oxidative stress; similar to Aft1p
Localization:
Intensity:
Fold change:
Significance:
-
C’ GFP library in SD
cytosol19.14 -
N' NOP1pr-GFP in SD

cytosol37.7644 -
N' TEF2pr-mCherry in SD

cytosol12.2176 -
N' NATIVEpr-GFP in SD
below threshold22.9944 -
N' TEF2pr-VC and Cyto-VN in SD

below threshold24.9167 -
C’ GFP library in SD+DTT

cytosol14.540.76No -
C’ GFP library in SD+H2O2

cytosol15.530.81No -
C’ GFP library in Starvation Media
cytosol16.520.86No -
C’ GFP library on the background of Pup2-DaMP

cytosol -
C’ GFP library on the background of CCT mutant

cytosol18.13770.947512No
